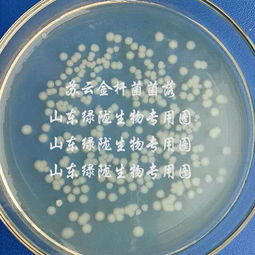
苏云金杆菌兑水比例 8000的苏云金杆菌使用浓度

苏云金芽孢杆菌在30克中加入多少水
苏云金芽孢杆菌与水的比例因植物不同而不同。
棉花、水稻和烟草400-500毫升/公顷;玉米300-400毫升/公顷;十字花科蔬菜200-300毫升/公顷。
使用苏云金杆菌的注意事项:
1.涂抹间隔15天左右,可连续使用两次;
2.使用时,需用清水配制药液,现配现用,不宜久配;
3.如果刮风或预计一小时后下雨,农药就不能施,否则会影响药效。
苏云金芽孢杆菌的作用、用法和用量,以及如何兑水
苏云金芽孢杆菌是目前广泛使用的生物杀虫剂。
苏云金芽孢杆菌具有特异性和对人畜有益的优点。
所以也是农民认可的。
那么,苏云金芽孢杆菌的作用是什么呢?用法用量以及如何混水?让我们来看看吧。
苏云金芽孢杆菌的作用。苏云金杆菌的商品名有青春灵、杀菌剂、果蔬网、菜虫特杀、康多惠等。
它是一种细菌杀虫剂,能产生内外毒素,主要是通过未读杀死害虫,当害虫吞咽后进入消化道时引起败血症,导致昆虫死亡。
对农作物无害,不杀死天敌,具有安全无毒的优点。
目前国内大部分苏云金芽孢杆菌乳剂中添加了拟除虫菊酯类杀虫剂,可以加快杀灭害虫,起到增效作用。
苏云金芽孢杆菌1的用法和用量。十字花科菜青虫、小菜蛾幼虫3龄前,每667m2用800IU/mg可湿性粉剂100-300g,1600IU/mg可湿性粉剂100-150g,或3200IU/mg可湿性粉剂50-80g,或2000。或4000IU/微升悬浮剂100-150毫升,或8000IU/微升悬浮剂50-75毫升,或100亿活孢子/克可湿性粉剂100 ~ 100克,加水30-45克,喷洒均匀。
2.在稻纵卷叶螟和水稻玉米螟幼虫的孵化高峰期达到3龄前,800IU/mg可湿性粉剂300-400克,1600IU/mg可湿性粉剂150 r-J200,3200IU/mg可湿性粉剂80-100克,或200克。
3.从棉铃虫和桥虫幼虫的孵化期到钻铃前,每667m2使用400-500克800IU/mg可湿性粉剂、200-250克16000g可湿性粉剂、120克32000IU/ mg可湿性粉剂或400-2000IU/微升悬浮剂。或8000IU/微升的悬浮液100-120毫升,或100亿活孢子/克可湿性粉剂250-400克,水45-75公斤混合后均匀喷洒。
4.玉米、高粱玉米螟每667m2使用800IU/mg可湿性粉剂250-300g,或400 iu/微升悬浮剂150-200ml,在玉米或高粱大喇叭口期喷施或拌入细砂,制成毒土填叶。
5.在高峰期,每667平方米应使用200-300克8000IU/ mg可湿性粉剂、16000iu/ mg可湿性粉剂、50-80克32000iu/ mg可湿性粉剂或2000iu/ μ l悬浮剂。
6.烟青虫幼虫3龄前喷施,每667平方米使用800IU/mg可湿性粉剂400-500克,1600IU/mg可湿性粉剂200-250克,32000IU/ mg可湿性粉剂100-120克,或2000IU/微升悬浮剂4000克。
7.从孵化高峰期起3龄前喷洒农药,使用8000IU/ mg可湿性粉剂100-150倍,或16000iu/ mg可湿性粉剂200-300倍,或32000iu/ mg可湿性粉剂400-500倍,或2000iu/微升悬浮剂80倍。
茶尺蠖幼虫在3龄前开始喷药,喷药次数与茶毛虫相同。
柑橘凤蝶幼虫在孵化高峰期开始喷药,喷药次数与茶毛虫苹果蠹蛾、梨树芒毛虫相同。
森林尺蠖、蛾、马尾松毛虫、美国白蛾从害虫发生初期就开始喷洒农药,喷洒次数与茶毛虫相同。
如何将苏云金杆菌与水混合?一般苏云金杆菌是5 ml水和15 kg水混合,也就是1: 3的比例。
苏云金芽孢杆菌是一种产生晶体的芽孢杆菌,它包括许多变种。它可用作微生物来源的低毒农药,主要用于防治鳞翅目昆虫幼虫。
微生物杀虫剂与水混合
吡虫啉属于吡啶类杀虫剂,具有触杀毒性和胃毒作用,还具有一定的渗透作用,主要用于防治蚜虫、粉虱等刺吸式口器害虫。目前市场上吡虫啉的含量主要有10%、20%、70%。我们以20%吡虫啉为例。每亩用量5-15g/亩,每亩喷水30-40kg。所以20%吡虫啉与水的比例为1∶2000-3000。
我家里养的一些农药和杀菌剂,便宜好用,预防和治疗效果都很好。
之前有个开花店的朋友跟我说,教别人种花的时候要有所保留,不然什么都教别人,对我没有任何好处。当然,我不这么认为。种花是一种爱好。我喜欢和更多的人一起种花,和更多的人分享实用知识。
在花卉栽培过程中,不仅要学习各种花卉栽培知识,还要多实践,不断改善植物养护环境。要让植物长得更好,养花最重要的因素是阳光、水和土壤,其次才是施肥。如果植物没有得到适当的养护,它们很容易感染病虫害。
如果植物通常保持强壮,它们抵抗病虫害的能力会更强。即使这些植物不小心感染了病虫害,它们也能自己恢复。今天给大家分享一些防治病虫害的技巧和用药方法。
上面有胖乎乎的毛毛虫
想了解一些常见的病虫害,一定要多学。有些朋友甚至分不清是植物感染还是害虫。这个要靠我们自己仔细检查。毕竟虫子是会动的,而病菌是由一些真菌或者病毒引起的,还是很容易识别的。
家里可以准备一些有容量的注射器或者量筒,在经常往药剂溶液中加水的时候可以保证比例的准确。当然你需要准备一些有刻度的杯子,最好准备一个小电子秤,精度0.1 g,有些药品是粉末状的,用电子秤称的时候很容易掌握比例。
有朋友买一些小袋包装的粉状农药,说明书上没说是多少倍兑水,而是每亩用多少克。小袋包装的杀虫剂,包括常见的吡虫啉,一般都是用30升水混合,因为农用喷雾器一般是30升,计算出来这些农药和水的比例是1:1500。这个剂量不能太大。
在喷药之前,你最好准备一个专门用来喷药的喷壶,而且最好有刻度,容量要在2升左右,所以用水喷药的时候最好掌握合适的容量。
在花卉栽培过程中,最常见的害虫有蚜虫、介壳虫、红蜘蛛、粉虱等。其他害虫包括毛虫、切叶虫(幼虫)和潜叶虫。
常见病害有黑斑病、炭疽病、根腐病、白粉病、灰霉病、炭疽病等。
我们平时需要准备的农药有:吡虫啉、阿维菌素、溴氰菊酯、麻竹(或蜱螨亚纲)、必治或噻虫嗪。
1.需要清除的常见杀虫剂和害虫
1.蚜虫清除:
和常见的蚜虫一样,是最好清除的害虫,也是辨识度特别高的一种。害虫会在各种花草上爆发,甚至是一些比较强壮的植物,包括常见的芙蓉花。
蚜虫和它们的主人蚂蚁在上面
蚜虫是胖乎乎的害虫,整个体型比较圆,除掉蚜虫也比较简单。一般用吡虫啉,喷一两次就能彻底除虫害。喷洒时,要注意均匀喷洒在叶背和全株上。
2.去除介壳虫:
如果不小心感染了介壳虫,一定要在幼虫的时候清除。当它们长成成虫时,它们的表面会长出一层壳,可以阻挡各种杀虫剂,所以清除起来非常困难。
如果你想除掉介壳虫,可以用普通的灭治或噻虫嗪。一般5~7天喷一次,连续喷3、4次,会带来很好的杀虫效果。
3.红蜘蛛移除:
另外,如果家里有月季,需要准备一些阿维菌素。如果不小心感染了蓟马,可以交替使用阿维菌素和吡虫啉来清理害虫,但要选择傍晚或夜间喷洒,因为蓟马是夜间活动的。
蓟马的识别度也比较高。白天都藏在花苞里或者叶底,都藏在嫩芽和叶子里。
提示:
通常我们在给植物花卉喷药的时候,可以在药店添加一些活性硅添加剂,也就是硅酮。当在喷雾过程中向药物中加入硅酮时,可以增加溶液的粘附性。当喷在叶子背面时,这些药物可以附着在叶子上形成一层非常均匀的薄膜,效果会更好。
上面有粉虱
当然,在喷洒农药的时候,这些化学物质也能很好的附着在蚜虫、红蜘蛛、介壳虫的表面,效果也很好。
例如,如果植物感染了介壳虫,可以使用噻虫嗪。但如果掺一些硅胶,去除害虫的效果会更好。请注意不要将吡虫啉和噻虫嗪混用。
4.黑蝇清除技巧
很多朋友反映,家里养的盆栽土壤里容易出现黑蝇。事实上,土壤太潮湿了。最好的防治方法是保持土壤干燥,多晒太阳,少用组内白药。
通常可以直接在农资店或者网上买到,包括常见的小白药或者小紫药。只要埋在土里,土里基本没有害虫。比如先在群体中撒一些小白药(呋虫胺、噻虫胺),就能很好的防止害虫的滋生。如果你已经有害虫,你可以使用它们。吡虫啉也撒在土壤表面,以后可以正常浇水。
如果是飞在空中的黑色小飞虫,可以准备一些黄色的竹节虫,挂在植物周围。这些小白药属于内吸式杀虫剂,价格相对便宜。常见的护花剂或吡虫啉也能去除黑蝇的成虫,往土里撒点吡虫啉就能解决。
二、杀菌剂及相应的病害
杀菌剂可在常用溶液中使用,如多菌灵、百菌清、甲基硫菌灵等。这些杀菌剂主要起预防作用。真的被真菌病感染后,再喷是没有效果的。
如果你的植物不小心感染了白粉病和黑斑病,这个时候喷洒多菌灵溶液根本没有效果。
上面有一朵感染了黑斑病的玫瑰
在此,再次提醒大家,多菌灵只有预防作用,此时可以使用三唑酮,这是一种比较好用的杀菌剂。
另一种常见的杀菌剂可以用地西泮,地西泮是消灭白粉病的有效杀菌剂,一般用3000倍水。比如1毫升水稳定时需要混入3000毫升清水中。可以加入2~3滴洗洁精,搅拌均匀,均匀喷洒在植物的叶片和背部,去除白粉病。
上面有一朵感染了白粉病的玫瑰
其他有效的杀菌剂还有代森锌和戊唑醇,能有效消灭黑斑病、灰霉病等真菌性病害。
这些杀菌剂都是比较好用的,但是要注意不要长期使用同一种杀菌剂,一定要两三种杀菌剂交替使用,以免这些真菌病害产生抗药性。同理,要交替使用农药,就是为了避免这些害虫产生抗药性。
如何将水与苏云金芽孢杆菌混合
一般5 ml水和15 kg水混合,也就是1: 3的比例。苏云金芽孢杆菌(Bacillus thuringiensis)是一种多品种的产晶体芽孢杆菌,可作为一种低毒的微生物源农药,主要用于防治鳞翅目昆虫幼虫。
